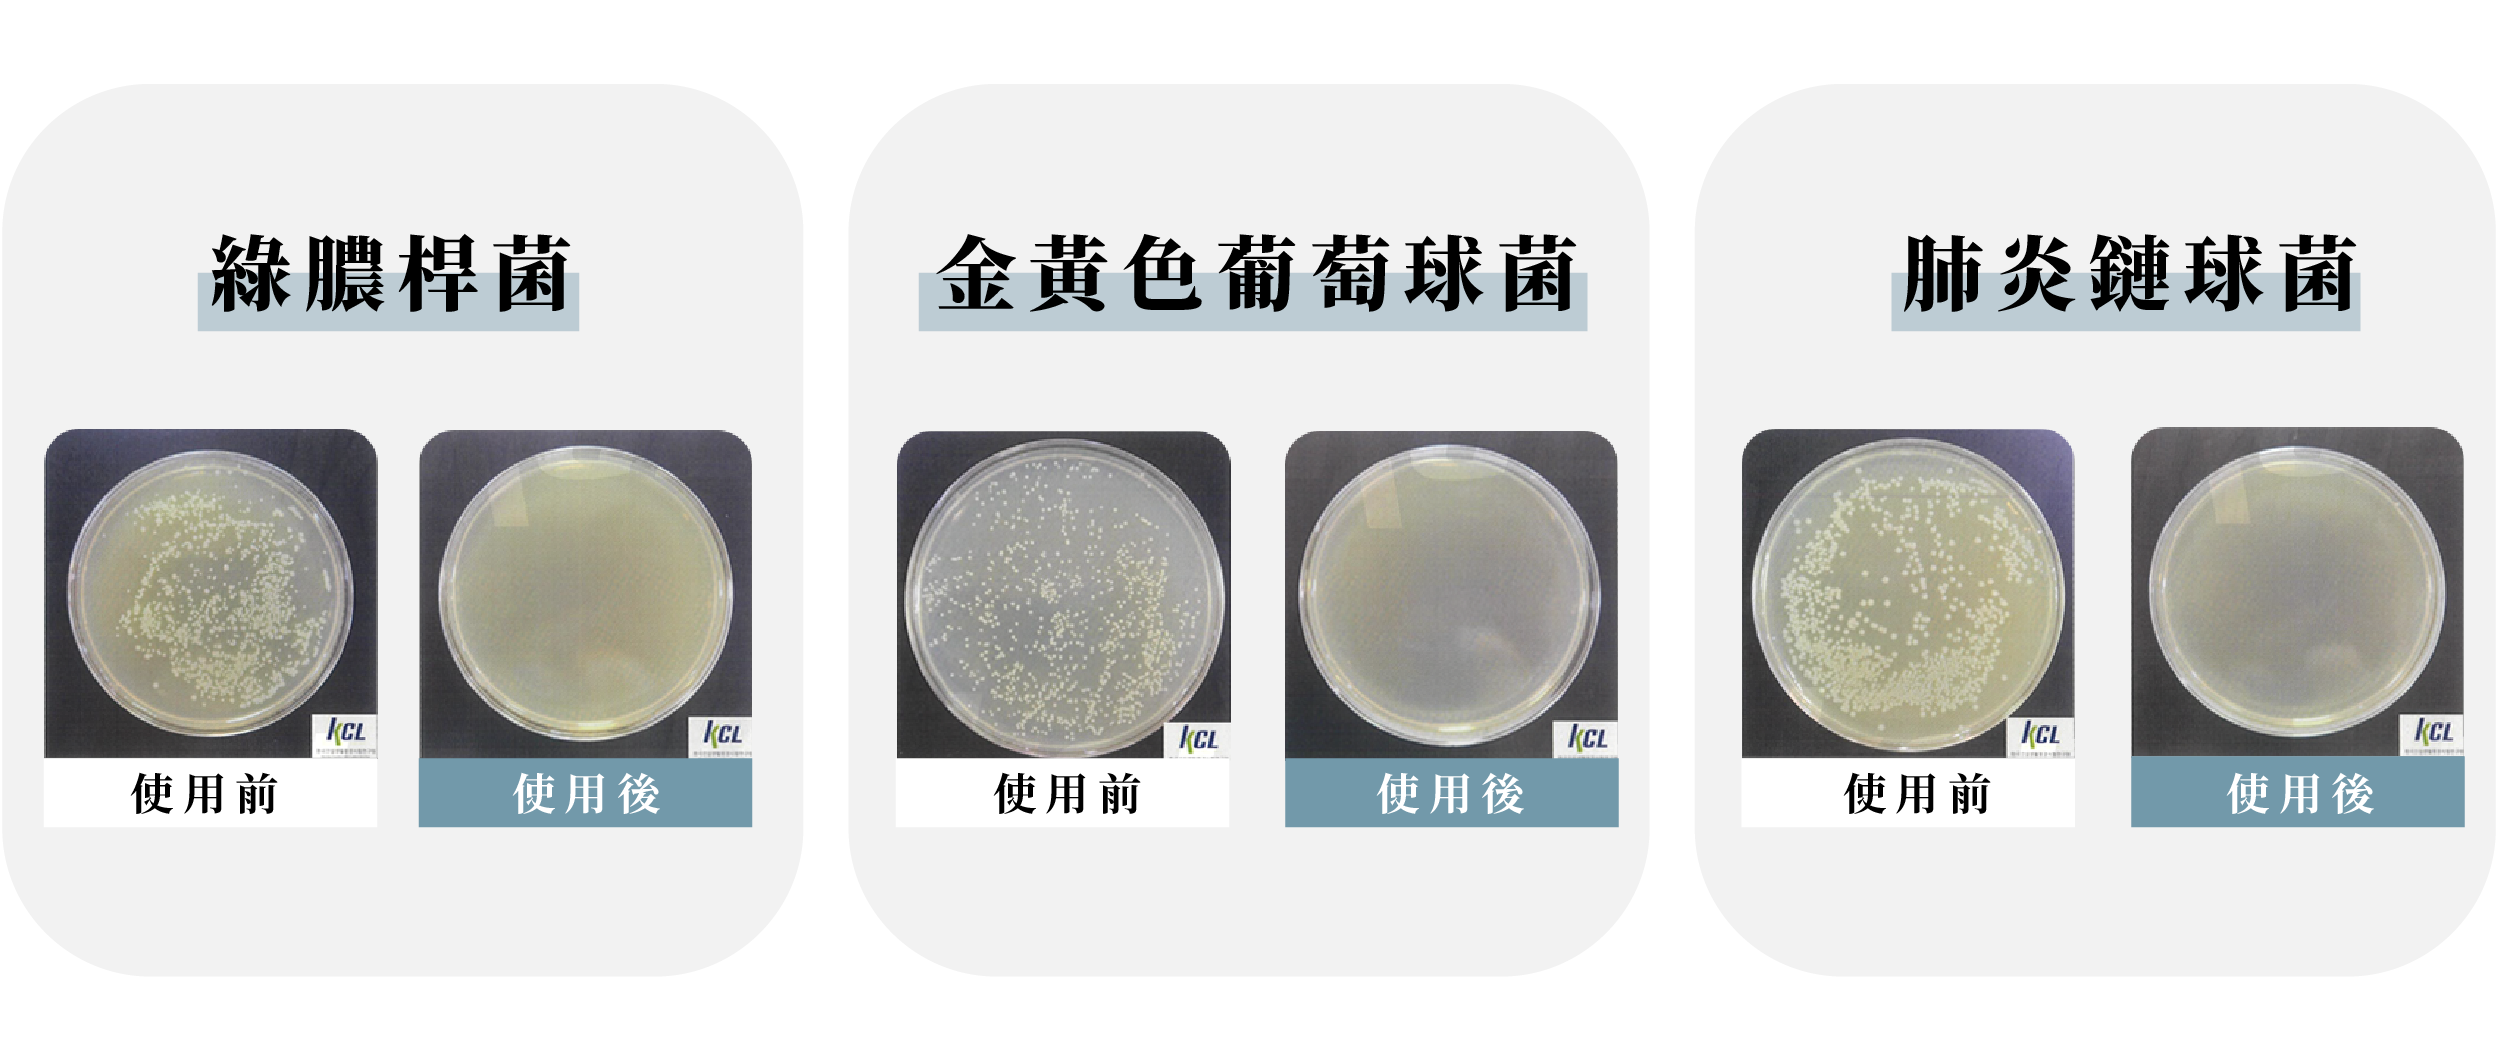

|
  

來自韓國的 ESTILO 連續 3 年獲得消費者喜愛家電用品大賞,致力於將笨重的大家電變方便。這次我們把電子衣櫥變得更方便、更好攜帶了!
寶貝的衣服,通通交給 ESTILO衣物護理機


      
使用高速蒸氣氣流比起一般蒸氣更強勁、更細膩。利用 PTC 加熱器的熱空氣還原,穿梭衣物從內到外,有效的深入衣服縫隙去除衣物上的異味。不管是去KTV還是吃完麻辣火鍋、燒烤,臭味都say byebye~
根據韓國衣物實驗研究院(KATRI)的除臭試驗結果顯示,有效將衣物上異味顆粒分子減少了98%。
*出貨時皆為中文面板
儲水槽可放入約210cc的水,填滿後可進行4~5次的標準管理唷!也可以加入1~2滴個人喜好的精油,為護理完後的衣物增添迷人香氣~

另外【ESTILO衣物護理機】內部上層設有香薰片放置處,想要放入喜歡的香薰片都可以唷~
 
【ESTILO衣物護理機】利用UV-C LED深紫外線,有效達到 99.9% 的高效殺菌。另外UV-C LED深紫外線擁有高穿透力,不放過衣物的任何一個死角~讓全家人穿上安心的呵護

*韓國KCL檢測中綠膿桿菌、金黃色葡萄球菌及肺炎鏈球菌都可達到99.9%的有效殺菌

|
比起笨重的大家電,ESTILO衣物護理機隨插即用,不需要再苦惱家中空間不夠,不僅展開使用方便,收納保管也超不佔空間~
【ESTILO衣物護理機】全機總重僅有5.2kg,臨時要帶外地出差,管理衣物也超方便,輕鬆收合機器一提就出門!
若僅靠單純的風力和蒸氣是很難徹底去除灰塵,也無法達到有效的衣物護理。所以經過3年的專業研究,我們採用獨特的震動技術與智慧掛勾。
每分鐘高達140次的振動,通過高速搖晃衣物來抖落的細小微塵。
智慧掛勾一次可以掛上2支衣架,搭配衣架上的夾子,可以放到4件衣物也沒問題唷~高速震動再搭配上蒸氣噴射的水霧,輕微的皺褶也能同時處理!
小TIP:將褲架夾在衣服下方增加重量,除皺效果會更好唷✨
對溫度敏感的衣物,西裝襯衫等,不同的衣服也需要不同的管理方法對吧!
所以我們也設置了五種操作管理模式,可以依照衣物與情境來分別使用唷
* 出貨時皆為中文面板
操作面板也非常簡單,插上電源後可長按模式選擇鍵即可切換模式,需要啟動時按下電源鍵即可,現在不需要複雜的過程也能輕鬆管理衣物啦~
最貼心的 ESTILO 為了大家使用上的安全,在拉鍊部分也做了感應裝置,拉鍊加入了感應磁鐵,須將拉鍊吸附在感應處,才有辦法啟動機器運作唷,因此不用擔心誤觸啟動機器!
不只這樣,在內部也設置了雙重過熱防止裝置,透過溫度感測器和安全性高的 PTC 加熱器來自動恆溫,防止機器過熱的情況發生!
ESTILO衣物護理機也是獲得了紅點設計大賞的產品,同時擁有高效且便利的設計,與任何空間都可以完美融合~